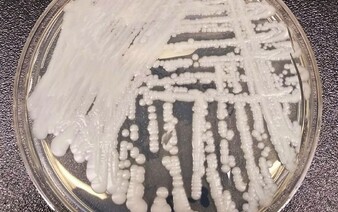

Smrtiaca kvasinka sa objavila aj v Česku.
Kvasinku Candida auris, ktorú Svetová zdravotnícka organizácia (WHO) považuje za jednu z najnebezpečnejších húb súčasnosti, zaznamenali aj v našom regióne. V Česku evidujú jeden potvrdený prípad z roku 2019, v Rakúsku hlásili dvoch nakazených a v Poľsku troch. Slovensko zatiaľ nezaznamenalo žiadny výskyt, no odborníci upozorňujú, že ide len o otázku času, keďže sa kvasinka rozšírila prakticky na všetky kontinenty, píše CNN Prima News.
Najvyšší počet prípadov hlásia v Európe Španielsko, Taliansko a Grécko. V Nemecku do roku 2022 diagnostikovali 27 prípadov nákazy. Hoci sa zatiaľ v strednej Európe šíri pomaly, zdravotnícke autority zbystrili pozornosť. Práve nemocnice, kde sa liečia imunitne oslabení pacienti, sú pre šírenie Candida auris ideálnym prostredím.
Táto kvasinka sa totiž správa úplne inak než väčšina známych húb. Je extrémne odolná voči dezinfekcii, bežným liekom proti mykózam a dokáže prežiť na povrchoch aj v prostredí dlhý čas. Spôsobuje závažné infekcie, ktoré môžu zasiahnuť centrálnu nervovú sústavu či vnútorné orgány. Až 60 % pacientov nákaze podľahne. Najviac sú ohrození starší ľudia, onkologickí pacienti alebo osoby po náročných zákrokoch.
Nie je isté, kde kvasinka vznikla
Vedci kvasinku prvýkrát identifikovali v Japonsku v roku 2009. Odvtedy sa rozšírila na všetky kontinenty s výnimkou Antarktídy. Kde presne vznikla, sa stále nevie. Svetová zdravotnícka organizácia ju zaradila na zoznam 19 najnebezpečnejších patogénnych húb.
„Hubové infekcie sa šíria čoraz viac a získavajú odolnosť voči liečbe, čím predstavujú globálnu hrozbu pre verejné zdravie,“ uviedla Hanan Balkhy, zástupkyňa generálneho riaditeľa WHO pre antimikrobiálnu rezistenciu.
Prečítaj si aj tieto články: